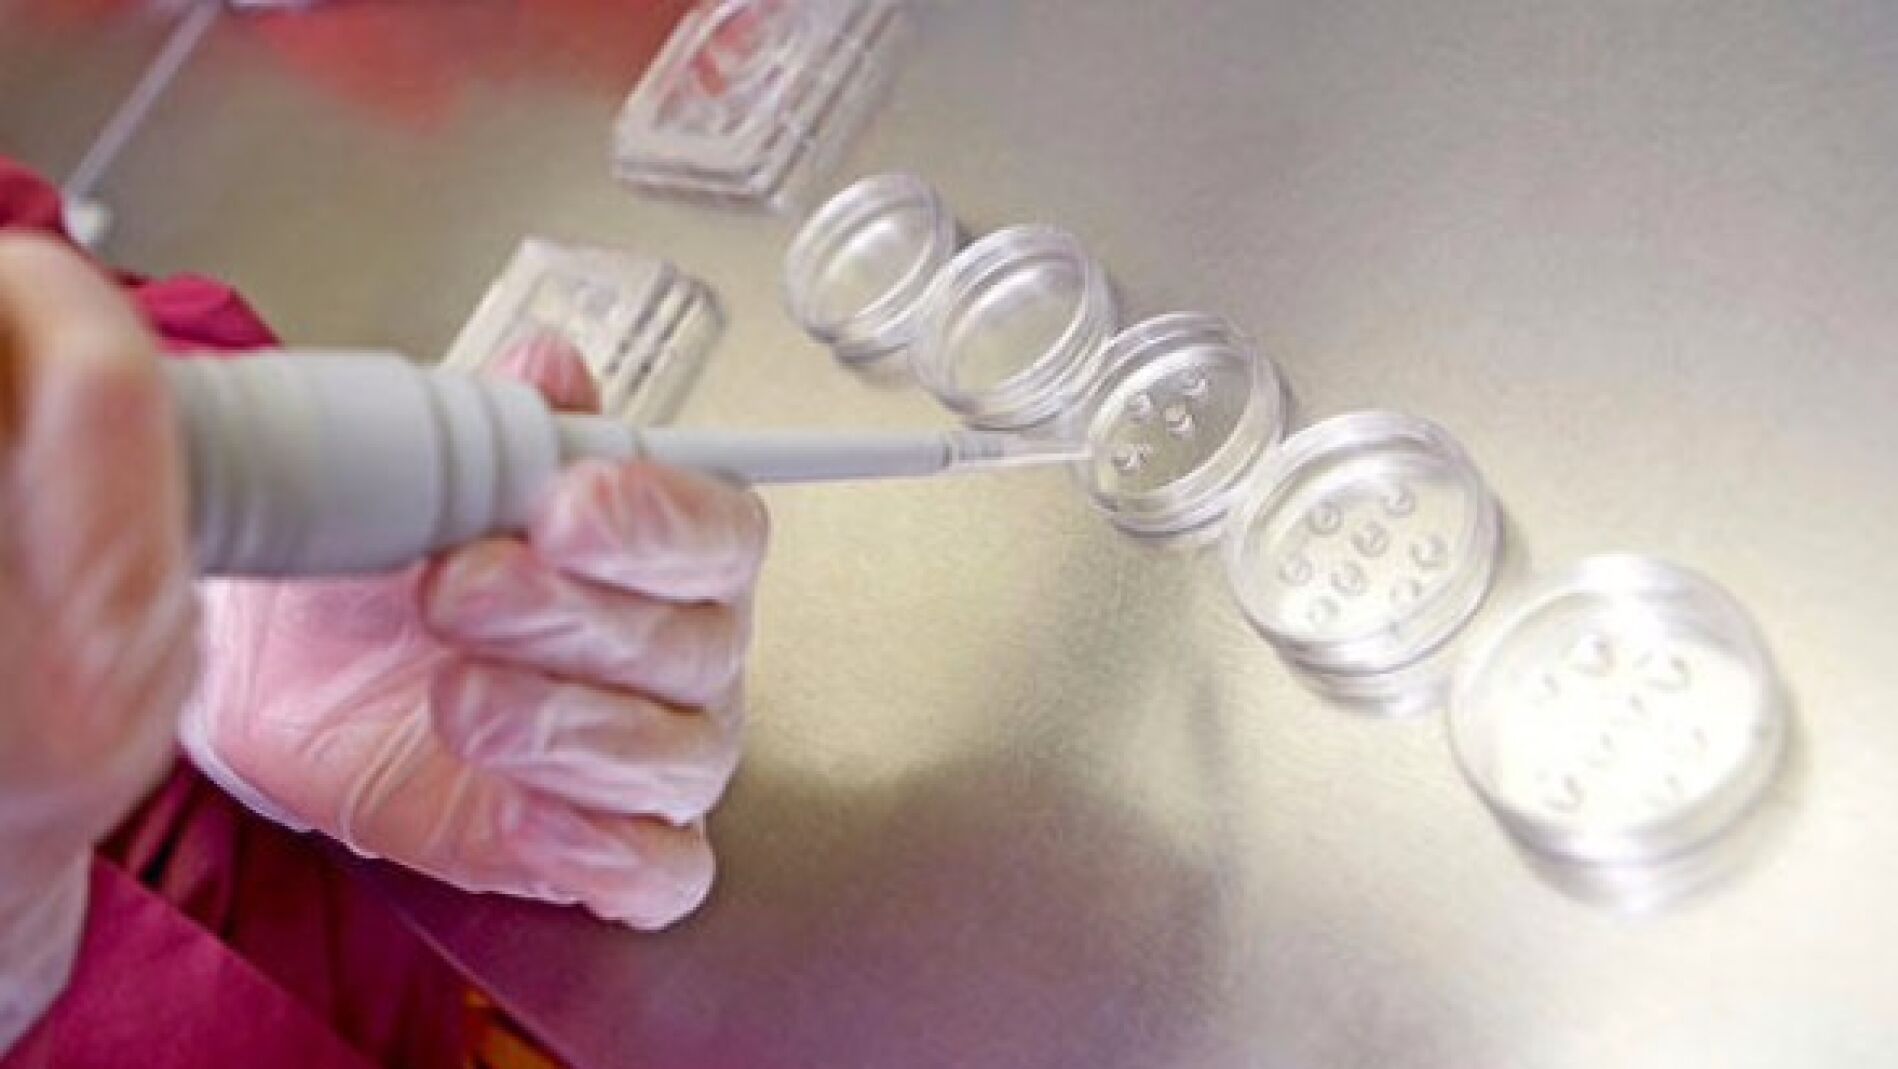
Laboratorio de t&eacute;cnicas de reproducci&oacute;n asistida

DATOS DEL MINISTERIO DE SANIDAD
España es el país de Europa donde más tratamientos de reproducción asistida se efectuaron
Según los datos del Registro Nacional de tratamientos de reproducción asistida en España, en el año 2014 se realizaron un total de 156.865 ciclos. El número de nacimientos fruto de estas técnicas ascendió a 33.934.
Publicidad
España se encuentra a la cabeza de los tratamientos de reproducción asistida en Europa al alcanzar en 2014 un total de 156.865 ciclos, de los que 116.688 fueron de fecundación in vitro (FIV) y 40.177 de inseminación artificial.
Son datos del informe del Registro Nacional de tratamientos de reproducción asistida en España, que se ha presentado este martes con las cifras de 278 centros que realizan este tipo de tratamientos, ha informado el Ministerio de Sanidad, Servicios Sociales e Igualdad en un comunicado.
El número de nacimientos fruto de estas técnicas ascendió a 33.934, una cifra que mantiene la tendencia a la baja de los partos múltiples de los últimos años, situándose en un 20,4%, señala Sanidad, que apunta que la Sociedad Española de Fertilidad es la encargada en los últimos años de gestionar el Registro de reproducción asistida.
En este sentido, el Ministerio sostiene que la transferencia de un único embrión es un objetivo de la comunidad científica con lo que en los últimos años las investigaciones en el campo de la fertilidad plantean métodos de selección embrionaria que mejoren la tasa de implantación y conseguir dejar atrás la transferencia de dos embriones.
De hecho, los investigadores están centrados en lograr que la reproducción asistida sea lo más parecida a un ciclo de reproducción natural, por lo que en 2014 se han conseguido las cifras más bajas de partos múltiples de la historia de la reproducción en España.
En total, en 2014 fueron transferidos un total de 85.626 embriones en 47.425 transferencias a partir de óvulos propios o de donantes, lo que significa una media de 1,8 embriones transferidos. Casi la mitad de los ciclos de FIV, el 47%, se realizaron en pacientes de entre 35 y 39 años, tanto con óvulos propios como procedentes de donantes. El 68% de las fecundaciones in vitro con donación de óvulos se hizo en pacientes mayores de 40 años, según el informe.
Respecto a la inseminación internacional, una técnica que requiere una buena calidad ovocitaria para que se produzca el embarazo puesto que la fecundación tiene lugar de forma natural, el 95 % corresponde a ciclos de mujeres menores de 40 años y un 6,5 % (2.627) a mayores de esa edad.
Publicidad








